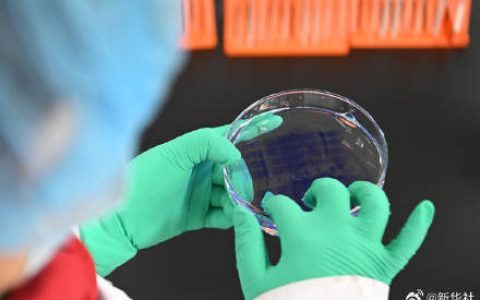
用药利好事关你我！国家医保药品清单一览

受冷空气及降雪影响,今天西北地区大部仍有小幅降温,南方随着雨雪收缩将开启回暖。明天,中东部大部都将加入升温的行列。
中东部气温起伏波动但由于冷空气实力弱,预计未来10天,北方大部到江南一带最高气温将维持偏高水平。9日至10日,气温将达到阶段高点,最高气温10℃线会逐渐北抬到河北中部,南方大部最高气温将超过15℃,较常年同期显著偏暖。
白天回暖明显,但夜间寒意不减,昼夜温差进一步拉大。尤其是江南多地将体验一日两季,湖北、湖南、江西、浙江部分地区温差可达15℃左右。大城市中,长沙10日最高气温将升至21℃左右,最低气温只有5℃,早晚时段出行需加强保暖措施。

来源:中国天气
免责声明:本站转载的文章,版权归原作者所有;旨在传递信息,不代表本站的观点和立场。